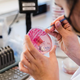

Epidemične razmere se v Sloveniji še naprej umirjajo. V sredo so potrdili 2336 okužb z novim koronavirusom ob 2000 PCR-testih in 15.542 hitrih antigenskih testih. Na navadnih oddelkih je zaradi …
Večer · 3L
Svetovna zdravstvena organizacija (WHO) je zavrnila vse glasnejše navedbe, da naj bi bila različica novega koronavirusa BA.2, ki je v bistvu podrazličica omikrona, nevarnejša od originalnega seva. Zaenkrat sicer še …
Regional · 3L

Svetovna zdravstvena organizacija (WHO) je danes zavrnila vse glasnejše navedbe, da naj bi bila različica novega koronavirusa BA.2, ki je v bistvu podrazličica omikrona, nevarnejša od originalnega seva. Zaenkrat sicer …
Primorske novice · 3L
Različiča, znana pod imenom "skrita grožnja". Nacionalni laboratorij za zdravje, okolje in hrano (NZLOH) je v zadnjem obdobju, od 7. 2. 2022 do 12. 2. 2022 sekvencioniral 706 pozitivnih vzorcev …
Žurnal24 · 3L

"Kako nevarna je različica BA.2? Nedvomno je še bolj kužna kot omikron BA.1," je danes na svojem profilu na Twitterju opozoril biokemik Roman Jerala s kemijskega inštituta. Podatki iz Južne …
Siol.net · 3L

Širjenje BA.2 , za katerega se domneva, da je 1,4-krat bolj nalezljiva kot že zelo prenosljiva originalna podrazličica omicrona, bi lahko zapletlo načrte za ponovno odpiranje, ki se trenutno izvajajo …
Insajder · 3L

Japonska laboratorijska študija kaže, da je omicronova različica BA.2 nevarnejša in bolj nalezliva od svojega originala. Tako kot omikron se tudi BA.2 dobro ogne imunosti po cepljenju, različici so kos …
Govori.se · 3L
pljučnicajaponska študijakoronavirusnevarnejšiomikornbolj nalezljivba.2

Japonska laboratorijska študija kaže, da je omicronova različica BA.2 nevarnejša in bolj nalezliva od svojega originala. Tako kot Omicron se tudi BA.2 dobro ogne imunosti po cepljenju, različici so kos …
Metropolitan.si · 3L
pljučnicajaponska študijakoronavirusnevarnejšiomikornbolj nalezljivba.2

Podrazličica se bi naj širila hitreje in povzročala hujši potek bolezni kot sam omikron. Za podrazličico omikrona BA.2 so ugotovili, da se širi hitreje kot sam omikron, nova raziskava pa …
Maribor24 · 3L

Podrazličica omikrona BA.2 se ne le širi hitreje od prvotne različie, temveč bi lahko bila tudi nevarnejša in bi lahko zaobšla ključna orodja, ki jih imamo proti covidu-19, kaže študija. …
RTV Slovenija · 3L